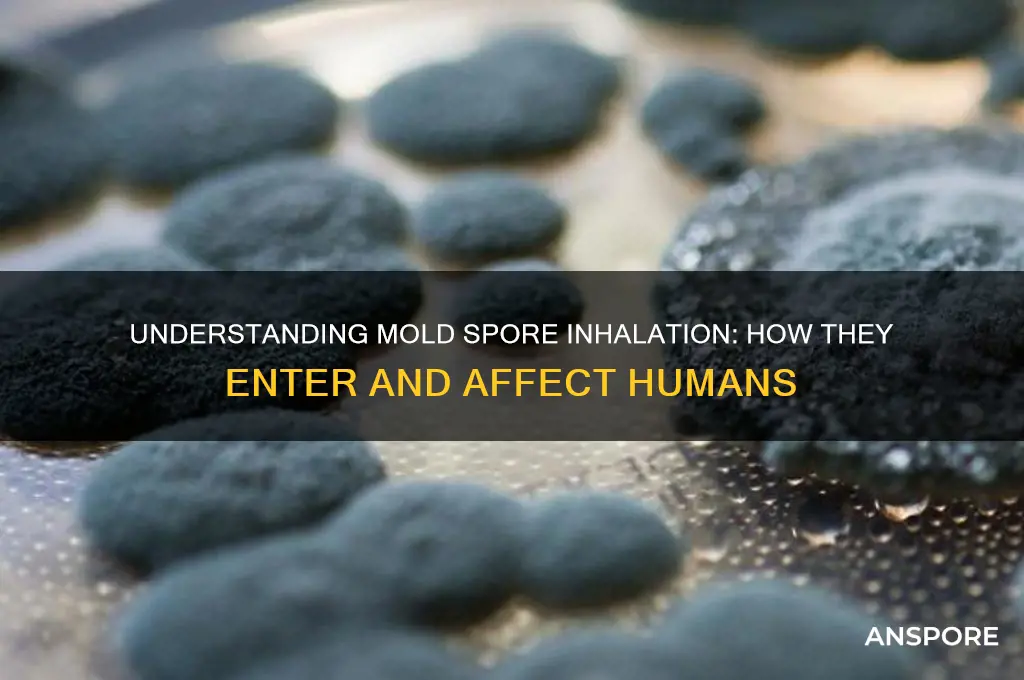
how do mold spores enter humans

Mold spores are microscopic particles that are ubiquitous in both indoor and outdoor environments, making them nearly impossible to avoid. These spores can enter the human body primarily through inhalation, as they are lightweight and easily become airborne, especially when disturbed. When mold-contaminated materials are touched or when moldy surfaces are cleaned without proper protection, spores can also settle on the skin or be ingested if hands come into contact with the mouth. Additionally, in rare cases, mold spores can enter the body through open wounds or cuts, though this is less common. Once inside the body, these spores can trigger allergic reactions, respiratory issues, or infections, particularly in individuals with compromised immune systems or pre-existing health conditions. Understanding how mold spores enter humans is crucial for implementing effective prevention and mitigation strategies to protect health.
| Characteristics | Values |
|---|---|
| Routes of Entry | Inhalation, Ingestion, Skin Contact, Eye Contact |
| Primary Route | Inhalation (most common) |
| Airborne Spores | Mold spores are lightweight and can remain suspended in air for hours |
| Particle Size | Typically 2-10 microns (easily inhaled into respiratory system) |
| Indoor Sources | Damp buildings, HVAC systems, carpets, wallpaper, furniture |
| Outdoor Sources | Soil, decaying organic matter, plants |
| Ingestion Risk | Low, but possible through contaminated food or water |
| Skin Penetration | Rare, but possible through cuts or prolonged exposure |
| Eye Irritation | Spores can cause redness, itching, or inflammation upon contact |
| Vulnerable Populations | Immunocompromised individuals, infants, elderly, asthma patients |
| Symptoms of Exposure | Allergic reactions, respiratory issues, skin irritation, infections |
| Prevention Measures | Maintain low humidity, fix leaks, ventilate, use air purifiers |
| Detection Methods | Air quality tests, visual inspection, mold testing kits |
| Health Risks | Allergies, asthma exacerbation, fungal infections (e.g., aspergillosis) |
| Seasonal Variation | Higher spore counts in warm, humid seasons |
| Occupational Exposure | Common in agriculture, construction, and HVAC workers |
Explore related products
What You'll Learn
- Inhalation through air: Breathing in mold spores from contaminated environments
- Skin contact: Direct exposure to mold on surfaces or materials
- Ingestion: Consuming food or water contaminated with mold spores
- Open wounds: Mold spores entering the body through cuts or injuries
- Mucous membranes: Spores entering via eyes, nose, or mouth linings

Inhalation through air: Breathing in mold spores from contaminated environments
Mold spores are ubiquitous in both indoor and outdoor environments, but their concentration in contaminated spaces poses a significant health risk through inhalation. When mold grows unchecked in damp areas—such as basements, bathrooms, or water-damaged buildings—it releases lightweight spores into the air. These spores, often invisible to the naked eye, can remain suspended for long periods, making them easy to inhale. The average person breathes in thousands of mold spores daily without issue, but in contaminated environments, the density of spores increases dramatically, elevating the risk of respiratory exposure.
The process of inhaling mold spores is insidious because it often goes unnoticed. Unlike larger particles, spores bypass the body’s natural defenses, such as nasal hairs and mucus, and travel deep into the respiratory system. Once inhaled, spores can settle in the nasal passages, throat, or lungs, depending on their size. Smaller spores (less than 5 microns) are particularly dangerous as they can reach the alveoli, the tiny air sacs in the lungs, potentially triggering inflammation or infection. Vulnerable populations, including children, the elderly, and individuals with compromised immune systems or pre-existing respiratory conditions, are at higher risk of adverse effects from prolonged exposure.
Preventing inhalation of mold spores in contaminated environments requires proactive measures. First, identify and address moisture sources that foster mold growth, such as leaks, humidity above 60%, or water damage. Regularly inspect areas prone to dampness, like crawl spaces, attics, and under sinks. Using air purifiers with HEPA filters can reduce spore concentration indoors, but this is a supplementary step, not a solution to underlying mold issues. When cleaning moldy areas, wear an N95 respirator to avoid inhaling spores during the process, and ensure proper ventilation by opening windows or using fans.
Comparatively, outdoor mold spore exposure is less concerning due to lower concentrations and better air circulation. However, indoor environments, especially those with poor ventilation, can trap spores, creating a persistent hazard. For instance, a study found that indoor mold spore counts can be 10 to 100 times higher in water-damaged buildings compared to outdoor levels. This disparity underscores the importance of maintaining dry, well-ventilated indoor spaces to minimize spore inhalation.
In conclusion, inhalation of mold spores from contaminated environments is a preventable yet often overlooked health risk. By understanding how spores enter the respiratory system and taking targeted steps to reduce exposure, individuals can protect themselves from the adverse effects of mold. Regular monitoring, moisture control, and proper protective equipment are key to mitigating this invisible threat.
Is Milky Spore Powder Safe? Potential Risks to Humans Explained
You may want to see also

Skin contact: Direct exposure to mold on surfaces or materials
Mold spores are ubiquitous, but direct skin contact with mold on surfaces or materials is a less discussed yet significant route of exposure. Unlike inhalation, which often grabs the spotlight, skin contact can lead to localized irritation, allergic reactions, or infections, particularly in individuals with sensitive skin or compromised immune systems. Everyday activities like handling damp clothing, touching moldy walls, or working with contaminated materials can facilitate this exposure. Understanding the risks and mechanisms of skin contact with mold is crucial for prevention and mitigation.
Consider the scenario of a homeowner cleaning a mold-infested basement. Without proper protective gear, such as gloves and long sleeves, mold spores can adhere to the skin, potentially causing redness, itching, or dermatitis. The risk escalates in environments with high mold concentrations, where prolonged exposure increases the likelihood of adverse reactions. For instance, Stachybotrys chartarum, commonly known as black mold, produces mycotoxins that can be absorbed through the skin, leading to more severe symptoms. Practical precautions, like wearing impermeable gloves and washing hands immediately after exposure, are simple yet effective measures to minimize risk.
Analyzing the biological interaction, mold spores on the skin can trigger immune responses in susceptible individuals. Allergic contact dermatitis, characterized by rashes, swelling, or blisters, is a common outcome. Interestingly, the severity of the reaction often depends on the mold species and the individual’s sensitivity. For example, children and the elderly, whose skin barriers may be less robust, are more vulnerable to such reactions. A study published in the *Journal of Allergy and Clinical Immunology* highlights that repeated skin exposure to mold can exacerbate pre-existing conditions like eczema or psoriasis, emphasizing the need for proactive protection.
To mitigate risks, follow these actionable steps: first, identify and avoid visibly moldy surfaces or materials. Second, use physical barriers like gloves and protective clothing when handling potentially contaminated items. Third, cleanse exposed skin promptly with mild soap and water to remove spores. For occupational settings, such as construction or remediation work, adhere to OSHA guidelines, which recommend using gloves made of nitrile or neoprene for better resistance to mold. Lastly, maintain indoor humidity below 60% to discourage mold growth on surfaces, reducing the likelihood of skin contact in the first place.
In conclusion, while inhalation dominates discussions on mold exposure, skin contact is a direct and often overlooked pathway. By recognizing the risks, understanding the mechanisms, and implementing practical preventive measures, individuals can significantly reduce their susceptibility to mold-related skin issues. Awareness and proactive protection are key to safeguarding health in mold-prone environments.
Growing Morel Mushrooms from Spores: A Comprehensive Guide
You may want to see also

Ingestion: Consuming food or water contaminated with mold spores
Mold spores can infiltrate the human body through ingestion, a route often overlooked yet surprisingly common. This occurs when individuals consume food or water contaminated with these microscopic fungi. Unlike inhalation, where spores enter through the respiratory system, ingestion introduces mold directly into the digestive tract, potentially leading to a range of health issues. Understanding this pathway is crucial for preventing exposure and mitigating risks.
Consider the everyday scenario of discovering mold on bread. While scraping off the visible mold might seem like a quick fix, it’s insufficient. Mold spores are invisible to the naked eye and can penetrate deep into food, especially porous items like bread, cheese, or fruits. Even small amounts of ingested spores can trigger allergic reactions, digestive discomfort, or, in severe cases, toxic responses. For instance, certain molds produce mycotoxins, such as aflatoxin, which are carcinogenic and can accumulate in the liver over time. Vulnerable populations, including children, the elderly, and immunocompromised individuals, are at higher risk of adverse effects from ingesting contaminated food.
Preventing mold ingestion begins with vigilant food storage and inspection. Store perishable items in airtight containers and maintain a refrigerator temperature below 40°F (4°C) to inhibit mold growth. Regularly inspect pantry staples like grains, nuts, and dried fruits, as these are prone to contamination. When in doubt, discard food rather than risking exposure. Water sources, too, require attention. Ensure drinking water is from a clean, reliable supply, and avoid consuming water from untested or stagnant sources, which can harbor mold and other pathogens.
Comparatively, while inhalation of mold spores is more commonly discussed, ingestion poses unique challenges. Inhalation typically affects the respiratory system, whereas ingestion impacts the gastrointestinal tract and, in severe cases, systemic health. For example, mycotoxin exposure through food can lead to long-term health issues like liver damage or weakened immunity. This underscores the importance of treating food safety as a critical component of mold prevention strategies.
In conclusion, ingestion of mold spores through contaminated food or water is a significant yet underrecognized route of exposure. By adopting proactive measures—such as proper food storage, regular inspection, and cautious consumption—individuals can minimize their risk. Awareness and prevention are key to safeguarding health in a world where mold is an ever-present threat.
Peristome Teeth: Enhancing Spore Dispersal in Plants?
You may want to see also
Explore related products

Open wounds: Mold spores entering the body through cuts or injuries
Mold spores are ubiquitous in the environment, and while they are typically harmless to healthy individuals, they can pose a significant risk when they enter the body through open wounds. These microscopic particles, often found in damp and humid environments, can infiltrate cuts, scrapes, or injuries, leading to localized or systemic infections. The risk is particularly heightened for individuals with compromised immune systems, such as those undergoing chemotherapy, living with HIV/AIDS, or taking immunosuppressive medications. Understanding how mold spores exploit open wounds is crucial for prevention and timely intervention.
Consider a scenario where a gardener pricks their finger on a thorn while working in a damp, mold-prone area. If the wound is not promptly and properly cleaned, mold spores present on the skin, tools, or surrounding vegetation can enter the body. Once inside, these spores can colonize the wound site, causing symptoms like redness, swelling, and pus formation. In severe cases, the infection can spread to deeper tissues or enter the bloodstream, leading to systemic conditions such as sepsis. For children and the elderly, whose immune systems are either developing or weakening, even minor wounds can become gateways for mold-related complications.
Preventing mold spores from entering open wounds requires vigilance and proactive measures. First, always clean wounds immediately with mild soap and warm water, ensuring all dirt and debris are removed. Applying an antiseptic solution, such as iodine or hydrogen peroxide, can further reduce the risk of infection. Keep wounds covered with sterile dressings, especially in environments known to harbor mold, like basements, bathrooms, or outdoor areas with decaying organic matter. For individuals with chronic conditions or weakened immunity, consulting a healthcare provider for specialized wound care recommendations is essential.
Comparatively, while respiratory inhalation is the most common route for mold spores to enter the body, open wounds provide a direct and often overlooked pathway. Unlike inhalation, where the spores must bypass the body’s natural defenses like mucous membranes and cilia, open wounds offer immediate access to deeper tissues. This makes wound care in mold-prone environments critically different from general mold avoidance strategies. For instance, wearing gloves while gardening or using protective gear in damp workspaces can significantly reduce the risk of spore exposure through injuries.
In conclusion, open wounds serve as vulnerable entry points for mold spores, particularly in environments where mold thrives. By understanding the risks and implementing targeted preventive measures, individuals can minimize the likelihood of infection. Prompt wound cleaning, antiseptic use, and protective barriers are simple yet effective strategies to safeguard against mold-related complications. Awareness and action are key to ensuring that even minor injuries do not become opportunities for mold spores to cause harm.
Hidden Dangers: Mold Spores Lurking in Your Carpet?
You may want to see also

Mucous membranes: Spores entering via eyes, nose, or mouth linings
Mold spores, ubiquitous in both indoor and outdoor environments, are microscopic particles that can infiltrate the human body through various pathways. Among these, the mucous membranes of the eyes, nose, and mouth serve as particularly vulnerable entry points. These moist, delicate linings are designed to protect and facilitate bodily functions but can inadvertently allow spores to penetrate, triggering allergic reactions, infections, or respiratory issues. Understanding how this occurs is crucial for mitigating exposure and safeguarding health.
Consider the mechanics of inhalation: when mold spores become airborne, they can be drawn into the nasal passages during normal breathing. The nasal mucosa, rich in blood vessels and mucus-producing cells, acts as a filter to trap foreign particles. However, its efficiency diminishes in environments with high spore concentrations, such as water-damaged buildings or mold-infested areas. For instance, prolonged exposure to spore levels exceeding 1,000 spores per cubic meter of air significantly increases the risk of nasal irritation and sinusitis. To reduce this risk, individuals should use HEPA filters in indoor spaces and wear N95 masks in mold-prone environments.
The eyes, another mucous membrane gateway, are particularly susceptible due to their constant exposure to the environment. Spores can land on the ocular surface during activities like gardening or cleaning moldy surfaces, leading to conjunctivitis or keratitis. A study published in *Clinical Ophthalmology* highlights that 15% of eye infections in humid climates are linked to mold exposure. Practical precautions include wearing goggles during high-risk activities and promptly rinsing eyes with saline solution if exposure is suspected.
Oral ingestion of mold spores, though less common, poses risks, especially in children and individuals with compromised immune systems. Spores can contaminate food or beverages stored in damp conditions, bypassing the mouth’s mucosal defenses. For example, bread stored in a humid environment can develop *Aspergillus* spores, which, if consumed, may cause gastrointestinal distress or systemic infections. To prevent this, maintain food storage areas at humidity levels below 50% and inspect perishables regularly for signs of mold.
In summary, the mucous membranes of the eyes, nose, and mouth are critical yet vulnerable entry points for mold spores. By understanding the specific risks associated with each pathway and implementing targeted preventive measures, individuals can significantly reduce their exposure and protect their health. Whether through environmental modifications, protective gear, or vigilant hygiene practices, proactive steps are essential in minimizing the impact of mold spores on the human body.
Microban's Mildew-Fighting Power: Can It Eliminate Stubborn Spores Effectively?
You may want to see also
Frequently asked questions
Mold spores primarily enter the human body through inhalation, as they are lightweight and can float in the air. They can also be ingested or come into contact with the skin or eyes.
A: While mold spores can land on the skin, they typically do not enter the body through intact skin. However, prolonged exposure or open wounds may increase the risk of skin irritation or infection.
A: Yes, mold spores can be ingested if they contaminate food or beverages. Consuming moldy items can introduce spores into the digestive system, potentially causing health issues.
A: Mold spores can irritate the eyes if they come into contact with them, but they do not typically enter the body through the eyes. Eye irritation or infections may occur with prolonged exposure.
A: Yes, the respiratory system is the most common entry point for mold spores. Inhaling spores can lead to allergic reactions, respiratory issues, or infections, especially in individuals with compromised immune systems.
























